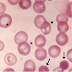

Schistosoma japonicum is an important parasite and one of the major infectious agents of schistosomiasis.This parasite has a very wide host range, infecting at least 31 species of wild mammals, including 9 carnivores, 16 rodents, one primate (Human), two insectivores and three artiodactyls and therefore it can be considered a true zoonosis.
- Disease
Schistosoma japonicum is the only human blood fluke that occurs in China. It is the cause of schistosomiasis japonica, a disease that still remains a significant health problem especially in lake and marshland regions. Schistosomiasis is an infection caused mainly by three schistosome species; Schistosoma mansoni, Schistosoma japonicum and Schistosoma haematobium. S. japonicum being the most infectious of the three species Infection by schistosomes is followed by an acute Katayama fever. Historical accounts of Katayama disease dates back to the discovery of S. Japonicum in Japan in 1904. The disease was named after an area it was endemic to, Katayama district, Hiroshima, Japan. If left untreated, it will develop into a chronic condition characterized by hepatosplenic disease and impaired physical and cognitive development. The severity of S. japonicum arises in 60% of all neurological diseases in schistosomes due to the migration of schistosome eggs to the brain.
- Morphology
The S. japonicum worms are yellow or yellow-brown. The males of this species are slightly larger than the other Schistosomes and they measure ~ 1.2 cm by 0.5 mm. The females measure 2 cm by 0.4 mm. The adult worms are longer and narrower than the related S. mansoni worms.
By electron microscopy there are no bosses or spines on the dorsal surface of the male, which is ridged and presents a spongy appearance. Many spines cover the inner surface of the oral sucker and extend to the pharyngeal opening. The oral sucker shows a rim with spines of variable size and sharpness inward and outward from the rim. The ventral sucker possesses many spines which are smaller than in the oral sucker. The lining of the gynecophoric canal is roughened by minute spines. The integument of the female is ridged and pitted and possesses fewer spines than in the oral sucker, the ventral sucker, and the gynecophoric canal of the male. Anterior to the acetabulum, the integumental surfaces are devoid of spines. However, in the other areas, spines are equally distributed except for the vicinity of the excretory pore.
The ova are about 55 - 85 μm by 40 - 60 μm, oval with a minute lateral spine or knob.
- Life cycle
The life cycles of Schistosoma japonicum and Schistosoma mansoni are very similar. In brief, eggs of the parasite are released in the feces and if they come in contact with water they hatch into free-swimming larva, called miracidia. The larva then has to infect a snail of the genus Oncomelania such as species of Oncomelania hupensis within one or two days. Inside the snail, the larva undergo asexual reproduction through a series of stages called sporocysts. After the asexual reproduction stage cercaria (another free-swimming larva) are generated in large quantities, which then leave (shed into the environment) the snail and must infect a suitable vertebrate host. Once the cercaria penetrates the skin of the host it loses its tail and becomes a schistosomule. The worms then migrate through the circulation ending at the mesenteric veins where they mate and start laying eggs. Each pair desposits around 1500 – 3500 eggs per day in the vessels of the intestinal wall. The eggs infiltrate through the tissues and are passed in the feces.
Life cycle of Schistosoma japonicum
- eggfemale discharges 500-3,5500 eggs per day into mesenteric venule of definitive host (human); the eggs eventually obstruct blood flow in the venule causing a partial necrosis in the intestinal wall; hence, the eggs are dropped of into the lumen of the intestine, and passed to feces; eggs measure ~80 X 60 µm in diameter, are oval to round in shape with subterminal spine
- miracidiuma free-swimming larva; once the egg is released into environment, miracidium hatches immediately and starts swimming; if it happened to swim into a snail of species Oncomelania, it enters the snail and starts its first life as a parasite
- sporocysta sac-like secondary larval stage; miracidium transforms into a primary (mother) sporocyst; germ cells within the primary sporocyst begin dividing to produce secondary (daughter) sporocysts, which migrate to the snail hepatopancreas; once at the hepatopancreas, germ cells within the secondary sporocyst begin to divide again, this time producing thousands of new parasites, known as cercariae, which are the larvae capable of infecting mammals
- cercariuman infectious form of Schistosoma which infects their hosts by direct skin penetration; cercariae emerge daily from the snail host; they are highly motile, alternating between vigorous upward movement and sinking; cercarium attaches to the human skin and secretes proteolytic enzymes helping it to enter into cuteneous capillary vessel; upon the penetration the cercarium sheds its tail and transforms into schistosomulum
- schistosomuluma tailless cercarium; after penetration schistosomula migrate to the lungs (in 3-4 days), and after passing through the pulmonary capillaries, enter the systemic circulation and, eventually, are carried to the mesenteric vein of the host; there they mature into adult schistosomes in a month; male schistosome holds female between its gynecophoral canal; at this time, the infection of the final host is complete and sexual reproduction of the parasite begins
- adultthe adult worms can live for years; male and female are always hugged together; up to half the eggs released by the worm pairs become trapped in the mesenteric veins, or will be washed back into the liver, where they will become lodged; trapped eggs mature normally, secreting antigens that elicit a vigorous immune response; schistosomiasis is a chronic desease characterized by abdominal pain, fever, anemia, hepatosplenomegaly; acute schistosomiasis (Katayama fever) may occur weeks after initial infection
- Pathology
Once the parasite has entered the body and begun to produce eggs, it uses the host’s immune system (granulomas) for transportation of eggs into the gut. The eggs stimulate formation of granuloma around them. The granulomas, consisting of motile cells, carry the eggs to the intestinal lumen. When in the lumen, granuloma cells disperse leaving the eggs to be excreted within feces. Unfortunately, about two-thirds of eggs are not excreted, instead they build up in the gut. This can lead to fibrosis in chronic cases. S. japonicum is the most pathogenic of the schistosoma species because it produces up to 3,000 eggs per day, ten times greater than that of S. mansoni.
As a chronic disease, S. japonicum can lead to Katayama fever, liver fibrosis, liver cirrhosis, liver portal hypertension, splenomegaly, and ascites. Some eggs may pass the liver and enter lungs, nervous system and other organs where they can adversely affect the health infected individual.
- Diagnosis
 Microscopic identification of eggs in stool or urine is the most practical method for diagnosis. Stool examination should be performed when infection with S. mansoni or S. japonicum is suspected, and urine examination should be performed if S. haematobium is suspected.
Eggs can be present in the stool in infections with all Schistosoma species. The examination can be performed on a simple smear (1 to 2 mg of fecal material). Since eggs may be passed intermittently or in small amounts, their detection will be enhanced by repeated examinations and/or concentration procedures (such as the formalin - ethyl acetate technique). In addition, for field surveys and investigational purposes, the egg output can be quantified by using the Kato-Katz technique (20 to 50 mg of fecal material) or the Ritchie technique.
Eggs can be found in the urine in infections with S. haematobium (recommended time for collection: between noon and 3 PM) and with S. japonicum. Detection will be enhanced by centrifugation and examination of the sediment. Quantification is possible by using filtration through a Nucleopore membrane of a standard volume of urine followed by egg counts on the membrane. Tissue biopsy (rectal biopsy for all species and biopsy of the bladder for S. haematobium) may demonstrate eggs when stool or urine examinations are negative.
Since the eggs of S. japonicum are small, concentration techniques may be required. Biopsies are mostly performed to test for chronic schistomiasis with no eggs. An ELISA test can be performed to test for antibodies specific to schistosomes. A positive result indicates a present or recent infection (within the past two years). Ultrasonographic examination can be performed to assess the extent of hepatic and spleen-related morbidity The problems with immunodiagnostic methods are that 1) It is only positive a certain time after infection 2) They can cross interact with other helminthes infections.
Microscopic identification of eggs in stool or urine is the most practical method for diagnosis. Stool examination should be performed when infection with S. mansoni or S. japonicum is suspected, and urine examination should be performed if S. haematobium is suspected.
Eggs can be present in the stool in infections with all Schistosoma species. The examination can be performed on a simple smear (1 to 2 mg of fecal material). Since eggs may be passed intermittently or in small amounts, their detection will be enhanced by repeated examinations and/or concentration procedures (such as the formalin - ethyl acetate technique). In addition, for field surveys and investigational purposes, the egg output can be quantified by using the Kato-Katz technique (20 to 50 mg of fecal material) or the Ritchie technique.
Eggs can be found in the urine in infections with S. haematobium (recommended time for collection: between noon and 3 PM) and with S. japonicum. Detection will be enhanced by centrifugation and examination of the sediment. Quantification is possible by using filtration through a Nucleopore membrane of a standard volume of urine followed by egg counts on the membrane. Tissue biopsy (rectal biopsy for all species and biopsy of the bladder for S. haematobium) may demonstrate eggs when stool or urine examinations are negative.
Since the eggs of S. japonicum are small, concentration techniques may be required. Biopsies are mostly performed to test for chronic schistomiasis with no eggs. An ELISA test can be performed to test for antibodies specific to schistosomes. A positive result indicates a present or recent infection (within the past two years). Ultrasonographic examination can be performed to assess the extent of hepatic and spleen-related morbidity The problems with immunodiagnostic methods are that 1) It is only positive a certain time after infection 2) They can cross interact with other helminthes infections.
 adult
adult

 egg
egg
 adult
adult




.jpg)

2 komentar:
thanks for such a useful information,i we give a try to his herb,i hope this also work for me.
please admin help me share this to those who still suffering of this ailment.
. As a sign of gratitude for how my wife was saved from Schistosomiasis, i decided to reach out to those still suffering from this.
My wife suffered Schistosomiasis in the year 2013 and it was really tough and heartbreaking for me because she was my all and the symptoms were terrible, she always complain of abdominal pain and swelling , and she always have skin itching. we tried various therapies prescribed by our neurologist but none could cure her. I searched for a cure and i saw a testimony by someone who was cured and so many other with similar body problem, and he left the contact of the doctor who had the cure to Schistosomiasis . I never imagined Schistosomiasis . has a natural cure not until i contacted him and he assured me my wife will be fine. I got the herbal medication he recommended and my wife used it and in one months time she was fully okay even up till this moment she is so full of life.Schistosomiasis has a cure and it is a herbal cure contact the doctor for more info on drwilliams098675@gmail.com on how to get the medication. Thanks admin for such an informative blog.
Posting Komentar